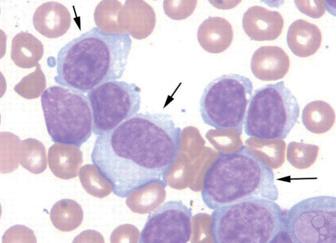
Атипичные лимфоциты в анализе крови у взрослых

Атипичные лимфоциты в анализе крови у взрослых
[Атипичные лимфоциты в анализе крови у взрослых]
[Атипичные лимфоциты в анализе крови у взрослых]
Атипичные лимфоциты в анализе крови у взрослых и у ребенка
Содержание
Атипичные лимфоциты могут возникать при некоторых заболеваниях. Многие считают, что их появление свидетельствует о наличии рака, но это не так. Такие лимфоциты свидетельствуют о наличии аллергии или инфекции. Лимфоциты — это разновидность лейкоцитов, которые отвечают за защиту органов от патогенных микроорганизмов. Они способствуют уничтожению и выведению из организма бактерий. Под воздействием некоторых из них лимфоциты меняют свои свойства и размер. Такое состояние не является нормальным и требует дополнительных исследований для выяснения причины проблемы и ее устранения.
Особенности атипичных лимфоцитов
Если в организме начинается патологический процесс, то уровень лимфоцитов возрастает. Такое состояние называют лимфоцитозом. Оно требует дополнительных обследований.
Лимфоцитоз может быть трех видов:
- реактивный. Он развивается, если защитные силы организма ослабевают. Тогда появляется большое количество атипичных клеток, которые обладают неполноценными свойствами;
- постинфекционный. Он возникает, когда человек вылечился от вирусной или инфекционной болезни;
- злокачественный. Это состояние возникает у людей, которые страдают онкологическими заболеваниями. При этом также вырабатывается большое количество атипичных белых кровяных телец.
Атипичные лимфоциты, появившиеся под воздействием антигенов, обретают такие характерные признаки:
- Меняется их размер. В обычном состоянии самые большие лейкоциты — макрофаги достигают в размере не более двенадцати микрометров. Лимфоциты очень редко имеют большие размеры, но под воздействием вирусов они могут вырастать до тридцати микрометров. Именно такими являются атипичные лейкоциты.
- В нормальном состоянии лимфоцит круглой формы. Когда структура клеток меняется, они могут становиться многоугольными с рваными гранями.
- Подвергаются изменениям и ядра лимфоцитов. В анализе крови можно обнаружить, что у атипичного лейкоцита ядро удлиняется и покрывается расщелинами, тогда как в обычном состоянии имеет круглую форму, удлиненную совсем незначительно.
- Меняется и цвет лейкоцитов. Так, процедура анализа крови включает определение окраса клеток крови. Для этого во взятый у пациента биоматериал добавляют гематоксилин и эозин. Это стандартные красители. Во время этой процедуры можно увидеть, что реактивные или атипичные лейкоциты имеют более яркий окрас, чем обычные. Они обретают темно-серый или синий цвет с фиолетовым ядром.
Существует несколько видов реактивных лейкоцитов.
Их назвали по именам ученых, которые их впервые обнаружили и описали:
- клетки Дауни. Их открыли в 1923 году. Ученый обнаружил эти клетки у больных, зараженных цитомегаловирусом или вирусом Эпштейна-Барра;
- клетки Ридера или амитотические лимфоциты. Они отличаются от других тем, что их ядро разделено пополам и имеет зазубренные контуры, а сама клетка почкообразной формы;
- клетка Боткина-Клейна-Гумпрехта. Над их описанием работали сразу трое ученых. Подобные лейкоциты обнаруживаются при лимфаденозе. Это мертвые клетки, которые некоторое время находятся в крови. Обнаружить их очень трудно, поэтому их еще называют тенями.
Почему они появляются
Наличие атипичных лимфоцитов чаще всего обнаруживают в крови у ребенка или взрослого при общем анализе крови, когда исследуют ее на уровень эритроцитов, лейкоцитов и тромбоцитов. Но они могут попадать также и в ткани.
У взрослого человека могут в крови обнаружить некоторое количество атипичных лейкоцитов даже при отсутствии заболеваний. Когда в организме начинает развиваться какая-то болезнь, уровень лимфоцитов возрастает, увеличивается количество и атипичных лейкоцитов.
Главные причины возникновения неправильных лейкоцитов — это вирусы и аллергии. Когда возбудитель болезни попадает в организм, то иммунитет начинает вырабатывать больше лимфоцитов, чтобы они могли справиться с проблемой. Если у человека иммунная система по каким-то причинам не может полноценно выполнять свои функции, то лейкоциты созревают не полностью, поэтому меняется их внешний вид и свойства.
Когда человек начинает выздоравливать ситуация улучшается и количество неправильных лимфоцитов уменьшается.
Атипичные лимфоциты могут развиваться под воздействием:
- Лимфолейкоза — это онкологическое заболевание, которое заключается в поражении злокачественными клетками лимфатической ткани.
- Бруцеллеза — это инфекция, которой страдают домашние животные. К человеку она попадает через продукты животного происхождения и поражает нервную и сердечно-сосудистую системы, а также кости и суставы.
- Некоторых стадий сифилиса — венерической инфекции, которая характеризуется поражением кожи, слизистых оболочек, внутренних органов, костей и нервной системы.
- Токсоплазмоза — инфекции, которая обычно протекает бессимптомно и вызывается токсоплазмами. Переносят инфекцию обычно кошки.
- Вирусных инфекций, например, пневмонии, ветрянки, которой чаще всего болеют дети, гепатита и других.
- Некоторых лекарственных препаратов, а также во время лечения иммунными сыворотками животного происхождения.
У детей атипичные лимфоциты и лимфоцитоз могут возникнуть при таких проблемах, как коклюш, полиомиелит, корь, малярия, при гриппе, ангине, острых респираторных инфекциях, менингите, воспалениях, которые сопровождаются выделением гноя, при онкологических заболеваниях.
Поэтому очень важно выявить проблему и ее причину на ранних этапах развития. Это значительно ускорит выздоровление и позволит избежать серьезных последствий для внутренних органов.
Что делать, если обнаружили лимфоциты реактивные
При обнаружении в крови атипичных лейкоцитов необходимо пройти дополнительные исследования, чтобы обнаружить причину возникновения этого явления. Только узнав, что вызвало отклонения, можно подобрать правильную терапию и вылечить пациента.
Могут использовать самые разнообразные методики и препараты.
Наличие в организме атипичных лимфоцитов свидетельствует о том, что иммунная система работает в напряженном режиме и ей необходима помощь, поэтому следует начать лечение, так как вирусы, которые вызвали это состояние, могут иметь достаточно серьезные последствия, особенно если заболел ребенок.
Какой-то определенной терапии нет.
Лечение зависит от симптоматики:
- если появились отеки, назначают противоаллергические препараты;
- при бактериальных инфекциях не обойтись без антибиотиков;
- желательно укреплять иммунитет. Для этого врач может назначить витаминно-минеральные комплексы, также необходимо вести здоровый образ жизни, правильно питаться, заниматься спортом.
Наличие атипичных клеток в анализе крови свидетельствует о том, что в организм попал вирус, поэтому при наличии такой проблемы необходимо обязательно выяснить причину изменения состава крови и принять соответствующие меры.
Атипичные лимфоциты
Атипичные лимфоциты в анализе крови у взрослых
Также не забывайте благодарить врачей.
гематолог5 12:24
Мне необходимо знать цифру тромбоцитов.
гематолог5 13:50
Судя по всему, это не гематология.
Оглавление:
Вы, видимо, переболели не ОРВИ, а инфекционным мононуклеозом, отсюда и такие клетки. У вас 3 выхода. Первый — на все наплевать. Второй- сдать кровь в лаборатории, где ее могут посмотреть специалисты (в лаборатории при гематологическом отделении). И третий, если не подходят первые два- пересдать анализ крови через месяц, но не на гематологическом анализаторе, а с ручным подсчетом формулы крови, что могут сделать в любой поликлинической лаборатории. Но не на анализаторе, которые и там стоят. Нужно чтобы посчитал врач-лаборант.
Надеюсь, после этого можно будет успокоиться.
Источник: https://03online.com/news/atipichnye_limfotsity_v_krovi/728
Атипичные лимфоциты
Атипичные лимфоциты в анализе крови: стоит ли паниковать?
Не секрет, что за борьбу с болезнями в нашем организме отвечают крохотные тельца, называемые антителами. За их выработку отвечает красный костный мозг — орган кроветворения, в недрах которого созревают новенькие иммунные клетки: лимфоциты, нейтрофилы, базофилы, эозинофилы и моноциты.
Главнейшим агентом иммунного ответа являются лимфоциты — их численность в крови преобладает над всеми остальными, именно с помощью них организм ведёт основную борьбу с инфекцией. Большинство лимфоцитов имеет правильную круглую форму и чёткие контуры, однако есть клетки, параметры которых немного отличаются от «оригинала». Такие клетки учёные называют атипичными.
Атипичные или реактивные лимфоциты — это особые иммунные тела, появляющиеся при аллергических реакциях, инфекционных и других заболеваниях. Неправильная форма и размер клеток обусловлены воздействием патогенных микроорганизмов, полностью меняющих их структуру. В норме атипичные иммунные тела не должны появляться вообще, а их наличие может указывать на развитие различных заболеваний.
В этой статье мы расскажем вам, что делать, если в вашем анализе крови обнаружены атипичные лимфоциты, поведаем о причинах, которые могли спровоцировать их рост.
В чём проявляется атипичность лимфоцитов?
Как известно, лимфоциты участвуют в процессах иммунного ответа — то есть, одни из первых бросаются на борьбу с опасными микроорганизмами. В результате этой борьбы они могут приобретать следующие параметры:
Обычно лимфоцит имеет круглую форму и ровные границы. Атипичные лимфоциты отличаются рваными контурами и неправильной многоугольной структурой.
В нормальном состоянии размер лимфоцита не превышает 12 мкм. Увеличение этого показателя говорит о его атипичности.
Воздействие патогенных организмов распространяется также и на ядро клетки — если посмотреть на неправильный агранулоцит через микроскоп, можно обнаружить, что оно вытянуто, удлинено, испещрено продолговатыми трещинками.
Атипичные лимфоциты также имеют более яркий окрас, при добавлении в анализируемую кровь красителя гематоксилина — это также один из способов выявления необычных клеток.
А вы знали, что черты характера человека влияют на его уровень сопротивляемости болезням? Есть исследование, подтверждающее, что активные и уверенные в себе люди вырабатывают большее количество клеток иммунного ответа, что и помогает им бороться с болезнями. Таким образом, оптимистичный и положительно настроенный человек имеет меньше поводов для беспокойства о своём здоровье.
Причины появления атипичных лимфоцитов
Многие люди, напуганные различными статьями в интернете и медицинских справочниках, уже на рефлекторном уровне начинают паниковать при виде слов «атипичный», «неправильный» и «мутагенный», ассоциируя их с онкологическими заболеваниями. Не спорю, повышенное число лимфоцитов, как и появление атипичных лимфоцитов, может являться косвенным симптомом рака, но это лишь одна из возможных причин, причём не самая распространённая.
Гораздо чаще к усилению выработки лимфоцитов приводит какая-либо инфекция или же аллергическая реакция. Такое явление называют лимфоцитозом. Медики различают три разновидности данного заболевания: реактивный, постинфекционный и злокачественный. Первые два связаны с ослаблением функций организма в результате инфекции, третий — с наличием опухолевого процесса в организме.
Лимфоцитоз неизбежно ведёт к образованию неправильных лимфоцитов, а точнее, он является одним из факторов, сопутствующих данной патологии. Причин у неё может быть несколько:
- Приём определённого круга лекарственных препаратов (к примеру, иммунных сывороток органического происхождения);
- Инфекционные заболевания: пневмония, ветрянка, гепатит и т.д.
- Бруцеллёз — заболевание, поражающее домашних животных. Попадая в организм человека через продукты питания, может вызывать нарушение в работе различных систем, в том числе и иммунной;
- Токсоплазмоз — заболевание без явной клинической картины, поражающее, однако, иммунные клетки организма и приводящее к возникновению реактивных лимфоцитов;
- Лимфолейкоз — злокачественное поражение лимфатических узлов, характеризующееся накоплением в них раковых клеток;
- Коклюш — заболевание дыхательных путей, сопровождаемое судорожным кашлем. Чаще всего встречается у детей;
- Сывороточная болезнь — аллергия на препараты животного происхождения;
- Сифилис на некоторых стадиях.
Уровень агранулоцитов в крови определяется общим анализом крови (на тромбоциты, эритроциты и лейкоциты). Сдаётся такой анализ обычно с утра и на голодный желудок.
Стоит отметить, что в крови взрослого человека можно обнаружить атипичные лимфоциты и при отсутствии патологического процесса в организме, поэтому так важно проконсультироваться с врачом насчёт результатов вашего анализа — именно он первым заметит неладное и посоветует, что делать в сложившейся ситуации.
Ещё одним немаловажным фактором развития атипичных агранулоцитов является аллергия. Врачи по всему миру твердят о том, что аллергические реакции станут одной из главных проблем, преследующих городских жителей в XXI веке. Дело в том, что в условиях экологических катаклизмов и загрязнённости воздуха, иммунная система человека начинает работать неправильно, «сбоить». Официальная статистика показывает, что уже сейчас число болеющих аллергией детей составляет 15%!
Норма атипичных лимфоцитов и лечение
В организме здорового человека может содержаться до 6 % атипичных лимфоцитов, большая часть из них консолидируется в кровеносной системе. Стоит встревожиться, если этот уровень превышает 7-10%, именно на это и необходимо указать своему врачу.
Лечение атипичных лимфоцитов, естественно, заключается в выявлении первопричины, а до тех пор не стоит прибегать к каким-то серьёзным мерам.
Чаще всего врачи назначают:
- Витаминно-минеральную терапию, укрепляющую иммунитет.
- Если заболевание имеет вирусную природу, соответственно назначаются антибиотики и противовирусные препараты.
- Антигистаминные и противоаллергические лекарства, если образование атипичных лимфоцитов спровоцировано аллергией.
Не стоит забывать также и о правильном питании, здоровом образе жизни и других мероприятиях, направленных на укрепление организма.
Лимфоциты — это группа иммунных клеток крови, подвид лейкоцитов, участвующая в борьбе организма с инородными телами и вирусами. Когда иммунная клетка сталкивается с серьёзной проблемой, его структура, размер и цвет могут меняться, и тогда можно говорить о развитии его атипичности. Норма атипичных лимфоцитов в крови человека составляет 6%, всё, что выше — свидетельствует о негативных изменениях в работе организма. Эти нарушения, в свою очередь, могут быть вызваны как вирусами, так и опухолевыми процессами, требующими немедленного лечения.
На этом всё, следите за состоянием своего организма, ведите здоровый образ жизни и не пускайте на самотёк имеющиеся проблемы, именно в этом и заключается секрет крепкого здоровья. Удачи!
Источник: https://www.sdamanaliz.ru/analiz-krovi/atipichnye-limfotsity.html
Атипичные лимфоциты: что это такое, и почему появляются?
Содержание
Особенности атипичных лимфоцитов
- реактивный. Он развивается, если защитные силы организма ослабевают. Тогда появляется большое количество атипичных клеток, которые обладают неполноценными свойствами;
- постинфекционный. Он возникает, когда человек вылечился от вирусной или инфекционной болезни;
- злокачественный. Это состояние возникает у людей, которые страдают онкологическими заболеваниями. При этом также вырабатывается большое количество атипичных белых кровяных телец.
- Меняется их размер. В обычном состоянии самые большие лейкоциты — макрофаги достигают в размере не более двенадцати микрометров. Лимфоциты очень редко имеют большие размеры, но под воздействием вирусов они могут вырастать до тридцати микрометров. Именно такими являются атипичные лейкоциты.
- В нормальном состоянии лимфоцит круглой формы. Когда структура клеток меняется, они могут становиться многоугольными с рваными гранями.
- Подвергаются изменениям и ядра лимфоцитов. В анализе крови можно обнаружить, что у атипичного лейкоцита ядро удлиняется и покрывается расщелинами, тогда как в обычном состоянии имеет круглую форму, удлиненную совсем незначительно.
- Меняется и цвет лейкоцитов. Так, процедура анализа крови включает определение окраса клеток крови. Для этого во взятый у пациента биоматериал добавляют гематоксилин и эозин. Это стандартные красители. Во время этой процедуры можно увидеть, что реактивные или атипичные лейкоциты имеют более яркий окрас, чем обычные. Они обретают темно-серый или синий цвет с фиолетовым ядром.
- клетки Дауни. Их открыли в 1923 году. Ученый обнаружил эти клетки у больных, зараженных цитомегаловирусом или вирусом Эпштейна-Барра;
- клетки Ридера или амитотические лимфоциты. Они отличаются от других тем, что их ядро разделено пополам и имеет зазубренные контуры, а сама клетка почкообразной формы;
- клетка Боткина-Клейна-Гумпрехта. Над их описанием работали сразу трое ученых. Подобные лейкоциты обнаруживаются при лимфаденозе. Это мертвые клетки, которые некоторое время находятся в крови. Обнаружить их очень трудно, поэтому их еще называют тенями.
Почему они появляются
- Лимфолейкоза — это онкологическое заболевание, которое заключается в поражении злокачественными клетками лимфатической ткани.
- Бруцеллеза — это инфекция, которой страдают домашние животные. К человеку она попадает через продукты животного происхождения и поражает нервную и сердечно-сосудистую системы, а также кости и суставы.
- Некоторых стадий сифилиса — венерической инфекции, которая характеризуется поражением кожи, слизистых оболочек, внутренних органов, костей и нервной системы.
- Токсоплазмоза — инфекции, которая обычно протекает бессимптомно и вызывается токсоплазмами. Переносят инфекцию обычно кошки.
- Вирусных инфекций, например, пневмонии, ветрянки, которой чаще всего болеют дети, гепатита и других.
- Некоторых лекарственных препаратов, а также во время лечения иммунными сыворотками животного происхождения.
Что делать, если обнаружили лимфоциты реактивные
- если появились отеки, назначают противоаллергические препараты;
- при бактериальных инфекциях не обойтись без антибиотиков;
- желательно укреплять иммунитет. Для этого врач может назначить витаминно-минеральные комплексы, также необходимо вести здоровый образ жизни, правильно питаться, заниматься спортом.
Источник: https://boleznikrovi.com/sostav/leykocity/atipichnye-limfocity.html
Что означают повышенные лимфоциты в анализе крови?
Повышение лимфоцитов в общем анализе крови частое явление. Необходимо найти и устранить причину лимфоцитоза, чтобы избежать различных осложнений.
Что такое лимфоциты: основные функции
Анализ крови на лимфоциты – делаем правильно!
Лимфоцит – это подвид лейкоцита, выполняющий в организме человека защитную функцию. Он делится на две большие группы: Т и В-лимфоциты:
- Т-лимфоциты или тимусзависимые составляют 70% от общей массы. Они стимулируют аллергические реакции замедленного типа, защищая от инородных веществ. Обладают прямым цитотоксическим эффектом – уничтожают собственные поврежденные и опухолевые клетки. Осуществляют противовирусное действие.
- В-лимфоциты отвечают за гуморальные иммунные реакции. Они способны превращаться в плазматические клетки, вырабатывающие иммуноглобулины, которые, в свою очередь, обороняют организм от вирусов, бактерий и аллергенов.
Лимфоцитоз – повышение абсолютного количества лимфоцитов более 5000 в 1 мкл (4,0×109л) и относительным содержанием среди лейкоцитов – 40%.
Для определения лимфоцитоза достаточно общего анализа крови.
Сдавать его необходимо натощак. Желательно за 12 часов до сдачи отказаться от жирной тяжелой пищи. За день до анализа отказаться от физической нагрузке. Не курить 2-3 часа.
При обнаружении повышенного уровня лимфоцитов необходимо сдать диагностический минимум:
- повторить кровь однократно
- сдать биохимическое исследование
- кровь на ВИЧ, гепатиты В и С, сифилис;
- сделать рентгенографию легких
- при необходимости пройти УЗИ органов брюшной полости и ФГС.
Основные причины лимфоцитоза
Высокий уровень лейкоцитов – признак заболевания!
Причины физиологического увеличения клеток:
- Менструация.
- Углеводное питание.
- Проживание в высокогорной местности.
Физиологический лимфоцитоз у детей – появляется как компенсаторная реакция на лимфопению (уменьшение количества клеток) родового стресса. Процесс продолжается до 8-10 лет, при наличии у ребенка анемии, истощения и рахита лимфоцитоз может затягиваться на несколько лет. У дошкольников максимум лимфоцитов – 9000/мкл, у школьников – 7200/мкл.
Патологический лимфоцитоз появляется в ответ инфекцию, активирующую клеточный иммунитет и при аутоиммунных процессах. В зависимости от формы и размера лимфоцита они делятся на атипичные и типичные. По атипичным можно предположить вероятное заболевание.
Болезни, вызывающие увеличение количества лимфоцитов:
С атипичными лимфоцитами:
- Инфекционные. Вызванные вирусным поражением: инфекционный мононуклеоз, герпетическая инфекция, цитомегаловирусная болезнь. опоясывающий лишай, ветряная оспа, вирусные гепатиты.
- Бактериальные инфекции: иерсиниоз, болезнь кошачьих царапин, листериоз.
- Паразитарные заболевания: токсоплазмоз.
- Асептические с нарушением в работе иммунитета: аллергические реакции замедленного типа (крапивница, дерматит) и резус-конфликт.
Заболевания с типичными лимфоцитами:
- Вирусные инфекции: корь, паротит, грипп, краснуха, аденовирусная инфекция, ВИЧ.
- Бактериальные: коклюш, туберкулез, сифилис, бруцеллез.
- Паразитарные заболевания, вызываемые простейшими организмами: малярия, трипаносомоз, лейшманиоз.
- Грибковое поражение: криптококкоз, кокцидиоз, споротрихоз.
- Связанные с патологией иммунной системы: с ывороточная болезнь, язвенный колит, эндокринные заболевания (базедова и аддисонова болезнь), аутоиммунные болезни (системная красная волчанка, синдром Шегрена).
Чем опасен лимфоцитоз?
Лимфоцитоз может указывать на очень опасные и серьезные болезни!
Симптомы повышения лимфоцитов будут зависеть от заболевания. Рассмотрим самые частые болезни, при которых возникнет лабораторный признак:
- Инфекционный мононуклеоз возникает при заражении вирусом Эпштейна-Барра (ВЭБ) из семейства герпес-вирусов. Типичные проявления: затруднение носового дыхания без отделяемого, боль в горле, резкое увеличение лимфоузлов, слабость, подъем температуры. По мере прогрессирования заболевания присоединятся симптомы поражения внутренних органов: высыпания на теле, желтушность кожи и склер, потемнение мочи и обесцвеченный кал. Интересный факт: клетки, зараженные ВЭБ становятся почти бессмертными и склонными к перерождению в злокачественные. Не исключено, что вирус Эпштейна-Барра причина лимфогранулематоза и носоглоточных карцином (злокачественный рак).
- Грипп, острые респираторные вирусные заболевания – признаки простуды знает каждый. Появляется слабость, ломота в мышцах, подъем температуры, кашель, насморк, головная боль. Лимфоцитоз благоприятный признак – организм активно борется с болезнью.
- Герпесвирусная инфекция начинается с выраженной слабости, сонливости, разбитости, увеличиваются лимфоузлы, на 2-3 день появляются пузырьковые высыпания. Локализация пузырьков разная: чаще губы, половые органы, туловище. При снижении иммунитета локализация будет нетипичная: нос, уши.
- Лимфоцитоз может быть первым признаком ВИЧ-инфекции, поэтому врачи при повышении лимфоцитов первым делом назначают анализ крови на ВИЧ и гепатиты В и С. Вирус иммунодефицита может до 10 лет после заражения циркулировать в организме, не вызывая симптомов. Небольшое беспокойство могут вызывать частые герпетические высыпания, простуды, опоясывающий лишай, периодическая слабость и сонливость. В период первых проявлений поднимается температура, увеличиваются лимфоузлы, развивается ангина, появляется диарея, головная боль. Человек может принять симптомы за обычную простуду, пролечиться лекарствами и забыть об инциденте. В дальнейшем больной постепенно теряет вес, длительно температурит, страдает от срывов стула, во рту появляются белые массы (грибковое поражение), красная кайма губ часто воспаляется (хейлит)
- Инфекционные заболевания (коклюш, корь, паротит) проявят себя мгновенно и ждать возникновения симптомов не приходится. Лимфоцитоз характерен для данной группы болезней, он сопровождается ускорением СОЭ и сдвигом нейтрофильных палочек влево – картина острого воспалительного процесса.
- Аутоиммунные заболевания – возникают на фоне патологического ответа собственных иммунных клеток на свои ткани. Системная красная волчанка проявит себя красной сыпью на лице в виде бабочки, где нос – спинка, а щеки – крылья. У больного наблюдаются подъемы температуры, боль в суставах, эрозии слизистой рта. Синдром Шегрена характеризуется сухостью слизистых: рта, носа, половых органов. По мере прогрессирования присоединяется сухость кожи.
- Рак крови – самый страшный диагноз при увеличении числа лимфоцитов. Лимфома – ряд заболеваний крови, возникающий из внекостномозговых лимфоидных клеток. Основные симптомы, идентичные для любого вида: выраженное увеличение лимфоузлов, потливость в ночное время, слабость, температура, утомляемость, одышка и кашель.
Повышение лимфоцитов у беременных женщин в большинстве случаев вызвано вирусными инфекциями. Необходимо быстро найти и устранить болезнь, поскольку любое воспаление опасно для плода и может привести к выкидышу.
Поскольку беременные особая категория людей, необходимо внимательно следить за анализами. Часто беременность провоцирует развитие онкологических заболеваний. Подозрительный лимфоцитоз, ускорение СОЭ, высокий уровень лейкоцитов, изменение формы лимфоцитов требует проверки на лимфому.
Лечение лимфоцитоза
Сначала обследование, потом лечение!
Лечение лимфоцитоза будет зависеть от причины болезни. Если он вызван простудными заболеваниями и картина крови долго остается неизменной, можно помочь организму. Необходимо принимать отвар девясила и подорожника по 1/3 ст 3р/д за полчаса до еды – травы обладают мощным противовоспалительным эффектом, улучшают кровь, снижают аллергизацию организма, способствуют повышению иммунитета.
При мононуклеозе лимфоцитоз длительный, больные в течение года часто болеют, отмечают слабость и вялость, нередко есть небольшая температура, сохраняется увеличение лимфоузлов. Здесь на помощь придет лимфомиозот – гомеопатический препарат, обладающий мощным противовоспалительным, противоотечным действием. Обеспечивает отток лимфы, вызывая уменьшение лимфоузлов, усиливает иммунную защиту. Можно использовать даже у детей, но под контролем врача. Взрослые применяют по 15 кап 3р/день через час после еды, предварительно растворив его в 1/3 стакана воды. Можно применять препарат исмиген – иммуностимулятор, обеспечивающий уменьшение воспалительной реакции. Применяется по схеме: 1 тб под язык 10 дней, затем 20-дневный перерыв. Курс повторяют 3 месяца. Нельзя ждать от исмигена мгновенного результата, он появится на 4-6 месяц.
Снизится частота простудных заболеваний, улучшится самочувствие.
Больше информации о лимфоцитах в крови можно узнать из видео:
Герпесвирусная инфекция требует общеукрепляющего лечения. Для усиления иммунитета можно принимать настойки: эхинацеи, аралии маньчжурской, женьшеня. Хороший иммуномодулирующий эффект оказывает настойка одуванчика лекарственного, отвар из листьев березы, ягод и листьев земляники и малины.
Болезни крови лечатся у онколога, самолечением заниматься нельзя. Применение лекарственных препаратов без ведома врача может вызвать ухудшение болезни.
Заметили ошибку? Выделите ее и нажмите Ctrl+Enter, чтобы сообщить нам.
Добавить комментарий Отменить ответ
В продолжение статьи
Мы в соц. сетях
Комментарии
- ГРАНТ – 25.09.2017
- Татьяна – 25.09.2017
- Илона – 24.09.2017
- Лара – 22.09.2017
- Татьяна – 22.09.2017
- Мила – 21.09.2017
Темы вопросов
Анализы
УЗИ / МРТ
Новые вопросы и ответы
Copyright © 2017 · diagnozlab.com | Все права защищены. г. Москва, ул. Трофимова, д. 33 | Контакты | Карта сайта
Содержание данной страницы исключительно ознакомительного и информационного характера и не может и не являет собой публичную оферту, которая определяется ст. №437 ГК РФ. Предоставленная информация существует с ознакомительной целью и не заменяет обследование и консультацию у врача. Имеются противопоказания и возможны побочные эффекты, проконсультируйтесь с профильным специалистом
Источник: https://diagnozlab.com/analysis/clinical-tests/blood/chto-oznachayut-povyshennye-limfotsity-v-krovi.html
Главное о лимфоцитах: атипичность и норма
Белые клетки крови – лейкоциты или WBC – являются основой иммунного барьера человека. Существует несколько видов кровяных телец этой группы. Все они осуществляют функцию защиты в организме человека, но работают по-разному: одни сигнализируют об опасности, другие – бросаются в бой и жертвуют собой в борьбе с чужеродными клетками микроорганизмов, третьи – вырабатывают антитела. Клетки WBC, выполняющие различную деятельность, отличаются ещё и по морфологическим признакам. Традиционно выделяют два звена:
- Кровяные тельца WBC со сложным ядром и наличием в цитоплазме гранул (называются гранулоцитами – базофилы, эозинофилы, нейтрофилы);
- Кровяные тельца WBC с простым ядром и цитоплазмой без зернистости (называются агранулоцитами – лимфоцитами и моноцитами).
В этот раз остановимся подробнее на лимфоцитах.
Содержание этой статьи:
Виды и функции
В организме женщин и мужчин рассматриваемые кровяные тельца являются главными составляющими иммунной системы. Существует несколько видов клеток:
Функции отличаются, поэтому рассмотрим каждый вид клеток по отдельности.
Т-клетки
Самую многочисленную группу кровяных телец этого вида составляют Т-киллеры. На протяжении жизни на клетки человеческого тела воздействуют различные патогены, некоторые из них приводят к заметному изменению их внутренней структуры. Т-киллеры участвуют в ликвидации повреждённых клеток собственного организма, выделяя уничтожающие их ферменты.
Вторую небольшую группу Т-лимфоцитов составляют Т-хелперы. Они отвечают за активацию Т-киллеров, выделяя специальные компоненты, стимулирующие размножение последних.
Чтобы в процессе интенсивной работы Т-киллеров не страдали здоровые клетки человеческого тела, их необходимо контролировать. В роли такого регулировщика выступают Т-супрессоры. Кровяные тельца сдерживают атаку Т-киллеров, тем самым не допускают развития аутоиммунных заболеваний.
Функция Т-лимфоцитов заключается в организации и координировании уничтожения непоправимо повреждённых клеток собственного организма. От 65 до 80 процентов всех лимфоцитов в крови женщин и мужчин составляют Т-клетки.
В-клетки
В лимфоциты воздействуют на инородные тела (микроорганизмы, частицы). Они распознают их, подбирают и выделяют агрессивные компоненты (белковые молекулы-антитела) для уничтожения чужеродных агентов. Такие вещества растворимы в плазме крови, поэтому назвали такой иммунитет гуморальным («гумор» означает жидкость).
В лимфоциты обеспечивают длительную память иммунитета. Единожды столкнувшись с вредящим агентом для организма, они запоминают и его, и механизмы борьбы с ним. После своей гибели В-лимфоцит передаёт всю информацию следующим поколениям клеток – именно поэтому, переболев «ветрянкой» в детстве, иммунитет сохраняется на всю оставшуюся жизнь. И также работает вакцинация – Б-клетки заносят информацию о болезнетворном вирусе или бактерии в свой «каталог», передают её приёмникам и уничтожают их при повторной встрече.
В крови их количество составляет порядка 8–20 процентов от общего числа лимфоцитов.
NK-клетки
Название этого вида кровяных телец происходит от английского natural killer, что означает «естественный убийца». Они в своих функциях дублируют Т-киллеры: уничтожают собственные клетки, повреждённые вирусами, бактериями или подвергшиеся генным мутациям (по сути – опухолевыми клетками). Количество натуральных киллеров в крови женщин и мужчин не превышает двадцати процентов (минимальное значение – 5%).
Образование клеток-лимфоцитов
Формирование лимфоцитов происходит в двух местах: вилочковой железе (тимусе) и лимфатических узлах. Наибольшее количество клеток формируется в тимусе порядка 80% (основная их часть Т-киллеры). Орган расположен в грудине, за её верхним краем. Вилочковая железа растёт до возраста 15-ли лет, увеличиваясь в своих размерах вдвое (от 15 г. в детстве до 30 г. в подростковом возрасте), затем наступает её постепенная атрофия и замена функциональных тканей жировыми. Самоуничтожение завершается примерно к 40 годам. В этом возрасте у мужчин и женщин наблюдается повышенная склонность к образованию опухолей и общим снижением иммунитета. Процессы характеризуются недостатком в крови Т-клеток лимфоцитов.
Лимфатические узлы располагаются по всей площади организма человека и отвечают за формирование В-лимфоцитов. С течением времени лимфоузлы не уничтожаются, поэтому В-лимфоциты и их значения не слишком варьируют на протяжении жизни.
Норма
Норма лимфоцитов в крови колеблется в зависимости от возраста человека, а не его половой принадлежности, поэтому у мужчин и женщин количество кровяных телец и их процентное отношение к общему числу лейкоцитов (WBC) остаётся примерно одинаковым.
В норме число кровяных телец достигает своих максимальных значений у младенцев и детей первого года жизни (от 2 до 11 млрд в литре крови), далее их значение постепенно снижается и после 18 лет находится в пределах 1–4,8 млрд на литр.
В анализе крови лимфоциты могут измеряться и в относительной величине – в процентах к числу WBC. У детей эти значения составляют 45–70% и постепенно снижаются, достигая своего минимума у взрослых мужчин и женщин – 19–37 процентов.
Норма лимфоцитов – важный критерий уровня здоровья человека. Пониженные значения указывают на состояние иммунодефицита и даже СПИД, а повышенные на усиленную работу иммунитета или аутоиммунные заболевания. В причинах отклонений помогают разобраться дополнительные исследования крови.
Атипичные кровяные тельца
Слово «атипичные» вызывает не лучшие ассоциации, но в случае лимфоцитов не стоит сразу пугаться. Нетипичные лимфоциты в норме не превышают уровня 6%. Атипичные лимфоциты (или реактивные клетки) визуально значительно отличаются от типичных кровяных телец.
- Клетки имеют общий увеличенный размер. Некоторые из них достигают 30 мкм и даже больше (в среднем – не более 12 мкм);
- Изменённые кровяные тельца имеют неправильную, угловатую, многоугольную форму. Нередко границы атипичных клеток выглядят «покусанными» или рваными (очертания нормальной клетки близки к окружности);
- Ядро может оставаться нормальным (практически круглым или слегка вытянутым) или иметь внешние дефекты: изъеденные края, расщелины и перетяжки, вытянутый или уменьшенный вид;
- Нетипичные тельца крови окрашиваются интенсивнее, имеют синий или серый цвет различной интенсивности и ярко-фиолетовое ядро.
Причины появления нестандартных лимфоцитов
Часто реактивные кровяные тельца добросовестно выполняют возложенные на них функции, несмотря на нестандартный внешний вид. Появление таких кровяных телец указывает на слишком интенсивную работу иммунитета, причиной которому заболевание. В условиях повышенной потребности в лимфоцитах их производство ведётся по ускоренной «технологии» и не все из произведённых кровяных телец достигают «кондиции» созревания – проявляется это в их несовершенном внешнем виде. После уничтожения большинства вредоносных агентов внешний вид большинства лимфоцитов приходит в обычную форму.
Наиболее частой причиной появления в кровотоке атипичных клеток-лимфоцитов является аллергическая реакция или респираторная инфекция. Повышение их числа может также указывать на более серьёзные патологии:
- Коклюш;
- Туберкулёз;
- Сифилис;
- Лимфолейкоз;
- Токсоплазмоз;
- Бруцеллёз;
- Сывороточная болезнь;
- Вирусное инфицирование.
Для диагностики заболеваний значение имеет не только количество клеток-лимфоцитов и их относительная величина, но и соотношение их разновидностей, а также наличие и удельное содержание атипичных форм. Комплексная оценка позволяет обнаружить патологии на ранних этапах и вовремя скоординировать дальнейшие диагностические мероприятия.
Источник: https://prokrov.ru/analiz-krovi/lejkocity/glavnoe-o-limfocitah-atipichnost-i-norma.html
О чем говорит наличие атипичных лимфоцитов в крови, и стоит ли волноваться?
Многие пациенты начинают интересоваться вопросом, что такое атипичные лимфоциты? после сдачи анализов в лаборатории. Само слово «атипичные» не вызывает положительных ассоциаций, поэтому у пациента появляется повод для волнений. Но паниковать не нужно. Такое заключение слышат многие взрослые и дети, но, как правило, ничего угрожающего оно не несет.
Внешние отличия атипичных лейкоцитарных клеток
Лейкоциты – главные агенты иммунитета. Они представляют собой многочисленный класс клеток, отличающихся друг от друга по строению и функциям. Особенность лейкоцитов состоит в том, что они происходят от разных типов клеток-предшественников, следствием этого становится их высокая полиморфность.
В процессе дифференцированного созревания лейкоциты разных видов приобретают характерные морфологические признаки и выходят в кровь. Пребывают они в кровотоке недолго, до двух дней, затем попадают в ткани. Поэтому при исследовании крови на уровень лейкоцитарных клеток микроскопии подвергаются только те клетки, которые на момент анализа находились в русле крови.
Во время анализа оценивается численность каждой популяции лейкоцитарной группы (гранулоцитов и агранулоцитов) и их морфологические признаки. В организме здорового человека морфологически лейкоциты не отличаются от стандартных форм и размеров. Но при определенных условиях (аллергии, инфекции, опухоли) в крови обнаруживаются атипичные лейкоциты с патологическими морфологическими признаками.
В микроскопе опытный лаборант сразу определит атипичные клетки по таким признакам:
- Нестандартная форма. Нормальные лимфоциты округлые. Атипичность клетки проявляется в рваном контуре или многогранной форме.
- Увеличенный или уменьшенный размер. Обычный размер лимфоцита – около 12 мкм. Атипичные формы могут достигать размеров моноцитов (до 30 мкм).
- Видоизменённое ядро. При оценке морфологии клетки смотрят на соотношение размеров ядра с объемом цитоплазмы. Незрелые нейтрофилы не имеют сегментированного ядра, а ядро атипичного лимфоцита, наоборот, может состоять из нескольких сегментов. Атипичные лимфоциты имеют увеличенную плазму, их называют плазматизированными. Базофильность плазмы говорит о молодости этих клеток.
- Нетипичное окрашивание клетки красителями, зернистость цитоплазмы. При обработке атипичных лимфоцитов эозиновым красителем они окрашиваются в синий цвет. Ядра становятся фиолетовыми. Нормальные лимфоциты после подкрашивания становятся жемчужными, сероватыми или желтоватыми.
Причины появления атипичных клеточных форм
Из основных факторов, которые становятся причиной появления лейкоцитарных клеток нетипичной формы, можно выделить четыре группы:
- Вирусные и бактериальные инфекции;
- Интоксикация организма;
- Ионизирующее излучение;
- Рак и генетические патологии.
Во всех этих случаях появление атипичных форм клеток сопутствует лейкоцитозу (усиленной выработке всех или отдельных популяций клеток), которое диагностируется по анализу крови со сдвигом влево (с преобладанием молодых незрелых форм клеток).
Характер механизма появления атипичных лимфоцитов может быть реактивным, инфекционным или злокачественным. Причем диагностика в первых двух случаях основывается на совокупности сопутствующих симптомов (недавние физические нагрузки, повышенная температура, другие характерные клинические признаки инфекционного заболевания). Эти механизмы наиболее распространенные. Третий – злокачественный механизм развивается намного реже и характеризуется появлением определенных типов атипичных клеток.
Важно! Если в крови обнаружены лейкоциты атипичных форм, это, в первую очередь, означает, что иммунная система пребывает в напряженном состоянии.
Виды атипичных лейкоцитарных клеток и причины появления
Реактивный лейкоцитоз возникает вследствие усиленного лейкопоэза. Этот процесс активируется в организме при помощи цитокинов, активных компонентов комплемента, в ответ на появление токсинов. В таких экстремальных условиях не все клетки созревают правильно, и неизбежно появляются атипичные формы реактивных лимфоцитов. В лаборатории атипичные клетки подсчитываются на каждые 100 клеток определенной группы
Дегенеративные изменения
Эта атипичная форма клеток появляется при длительной и интенсивной интоксикации организма. В лейкоцитах накапливаются отложения токсических веществ, и клетка утрачивает способность делиться и выполнять свои функции. Эти вещества могут иметь разную природу (жировые, пигментные). Такие клетки отличаются увеличением количества и размеров вакуолей (вакуолизация), появляется токсогенная зернистость цитоплазмы. Изменения размеров может быть в большую или меньшую (сморщивание) сторону. Такие изменения обычно связаны с тяжелым сепсисом, абсцессами, дистрофией печени.
При дефиците витамина B12 или недостатке фолиевой кислоты в крови обнаруживают гиперсегментированные нейтрофилы. Их ядра могут содержать до 6 сегментов.
Атипичные мононуклеары
Называются клетками Дауни или лимфомоноцитами из-за морфологического сходства атипичных лимфоцитов этого типа с моноцитами. По размерам они крупнее обычных лимфоцитов, имеют моноцитарное ядро. Эти клетки чаще всего обнаруживают в крови.
У абсолютно здорового человека атипичные мононуклеары не встречаются, но они всегда сопутствуют вирусным заболеваниям. Наиболее частая причиной такого состояния – одна из форм вируса герпеса.
Этот тип атипичных лимфоцитов – один из маркеров мононуклеоза. Если иные заболевания (токсоплазмоз, грипп) способны стать причиной появления нетипичных мононуклеаров до 7% от общего количества лимфоцитов, то превышение количества атипичных клеток этого типа 10% говорит о мононуклеозе.
Это заболевание с ярко выраженными катаральными симптомами и сопутствующими положительными результатами по выявлению атипичных мононуклеаров производит на родителей угнетающее впечатление. Но на самом деле оно не несет ничего угрожающего и после выздоровления лейкоциты в крови у ребенка и их морфология самостоятельно приходит в норму.
У детей количество атипичных мононуклеаров (вироцитов) в крови не превышает 1%. Увеличение их количества может быт следствием прививок либо указывать на недавно перенесенное заболевание.
В крови взрослого человека тоже могут быть обнаружены атипичные мононуклеары, так как с возрастом вероятность носительства вируса герпеса повышается, и к старости достигает 98%. Еще патологические клетки могут появляться в результате аллергических реакций.
Важно! Лечение препаратами сыворотки крови тоже может стать причиной усиления лейкопоэза.
При мононуклеозе диагноз ставится по сопутствующим клиническим признакам, наличию плазматизированных мононуклеаров. Механизм их появления носит инфекционный характер, и после выздоровления картина крови нормализуется.
Клетки-тени Боткина-Гумпрехта
Это фрагменты лимфоцитов или других лимфоидных клеток, их остатки, которые появляются в результате лейколиза в процессе приготовления материала для микроскопии. Такое явление говорит о высокой скорости разрушения лимфоцитов и всегда сопутствует хроническому лимфолейкозу, но встречается и при других инфекционных заболеваниях. Под микроскопом видны хроматиновые тяжи, голые или полуразрушенные ядра. Эти фрагменты и называют тельцами Боткина-Гумпрехта.
Клетки Ридера
Это почкообразные клетки с зазубренным контуром ядра. Обнаруживаются при лейкемии, пернициозной анемии, тяжело протекающих инфекциях, отравлениях свинцом или фосфором.
Норма атипичных лимфоцитов, меры по нормализации
Организм взрослого человека постоянно подвергается атакам чужеродных агентов, поэтому тонус иммунной системы может меняться. Атипичные лимфоциты в анализе крови могут появляться в зависимости от текущей нагрузки на иммунитет. Допустимая норма – не выше 6%. Внимания заслуживают показатели выше 7%.
Специфической терапии для нормализации уровня атипичных лейкоцитов нет, так как это явление становится следствием какой-либо патологии. Поэтому лечение направлено непосредственно на борьбу с заболеванием или устранение причины (аллергических факторов, прекращение приема лекарственных препаратов, сывороточных компонентов крови). Для лечения бактериальных инфекций назначают антибиотики, аллергические реакции купируют антигистаминными препаратами.
Болезнь Эпштейн-Барра (вирус герпеса IV типа) у взрослых часто протекает бессимптомно и специфического лечения не имеет. Сама болезнь не несет угроз, зато опасность представляет способность вируса вызывать злокачественные опухоли. При ослабленном иммунитете болезнь носит рецидивирующий характер, который может проявляться синдромом хронической усталости, развиться в лимфогранулематоз, лимфому, рассеянный склероз. Такие состояния требуют длительной терапии по коррекции иммунной системы.
Популярное видео, как работает иммунитет:
Вместе с тем пациентам рекомендуется нормализовать режим и рацион, что благотворно повлияет на потенциал иммунитета.
Источник: https://lechiserdce.ru/leykotsityi/6223-atipichnyih-limfotsitov.html
Стандартный развернутый анализ крови: расшифровка
Лейкоцитарная формула — это количество лейкоцитов, которые содержатся в крови пациента относительно стандартного их содержания. Данные даются в процентах. Такое определение дает Википедия. Анализ может соответствовать норме или нет. В случае нарушения лейкограмма будет сдвинута вправо или влево. Лейкоцитарная формула — это результат, который можно получить, сделав развернутый анализ крови. Такое исследование необходимо проходить хотя бы несколько раз в жизни. Этот анализ позволяет выявить наличие воспалительных процессов в организме, уровень гемоглобина и других элементов.
Расшифровка нейтрофилов
Нейтрофилы — это клетки плазмы, которые преимущественно образовываются в костном мозге и содержат в своем составе гранулы. У взрослых и детей такой элемент в обязательном порядке должен находиться в крови. Если нейтрофилы повышены, то это свидетельствует о наличии серьезного отклонения, которое необходимо лечить. У взрослых пациентов уровень таких клеток может колебаться в значении от 45% до 70% от общего содержания всех лейкоцитов в анализе. Если нейтрофилы повышены, то это значит, что в организме человека происходит воспалительный процесс. При таком результате анализа пациенту предлагают пройти ряд других исследований, которые подтвердят предположительный результат. После этого врач может назначить лечение.
Для детей такой показатель не является нормой. Количество элементов в их анализе сопособно до определенного возраста увеличиваться. А их количество на данный момент может быть обусловлено рядом факторов, которые влияют извне, или просто процессом взросления организма. Но если нейтрофилы понижены, то это говорит о том, что некоторые процессы происходят неправильно в организме ребенка и что-то тормозит его естественное развитие. Такой показатель требует немедленного продолжения диагностики, выявления причины подобного содержания элементов и ее устранения. Если нейтрофилы понижены, то такой результат может свидетельствовать о нарушении работы иммунной системы и ослаблении защитной системы организма.
Содержание моноцитов
Не менее важен уровень содержания моноцитов в крови пациента. Для взрослого человека нормальное содержание такого элемента не должно превышать 8%. Для детей эта норма ниже — до 7%. Это обусловлено тем, что в период взросления организм может терять некоторые необходимые вещества. Но в среднем данный показатель относительно стабилен, и абсолютное содержание моноцитов в крови у детей пропорционально количеству лейкоцитов. Сначала содержание может быть 2%, но до полного созревания организма данный показатель будет постепенно увеличиваться.
Если у пациента моноциты повышены, то это говорит о наличии моноцитоза. Это заболевание может быть абсолютным либо относительным. При относительной форме содержание элементов сохраняется в пределах общей нормы в крови, но их процентное содержание больше 8. Относительный моноцитоз может появляться за счет уменьшения содержания других элементов в крови. Абсолютная форма заболевания предусматривает повышение уровня элемента по всем возможным показателям. Развернутый анализ крови позволяет точно узнать наличие элемента и подтвердить или опровергнуть диагноз.
При повышении моноцитов в организме пациента могут развиваться гранулематозные болезни. К ним относится туберкулез, колит, сифилис, язва. Провоцировать повышение элементов могут инфекционные, вирусные и грибковые заболевания. Такие заболевания крови, как лейкоз, миелолейкоз, лимфогранулематоз, могут провоцировать отклонение процентного отношения моноцитов от нормы. Довольно часто у пациентов с таким нарушением наблюдается артрит или полиартрит.
Анализ на лимфоциты
У здорового взрослого человека нормальное наличие лимфоцитов в крови должно колебаться от 25 до 40% от общего уровня лейкоцитов. В детском возрасте показатель может быть абсолютно другим. Он будет колебаться в зависимости от возраста ребенка и степени его развития. При анализе крови на лимфоциты нужно быть готовым к тому, что результат может отклоняться от нормы. Это может обычно происходит у беременных женщин или у детей. Для беременных процентное содержание обычно повышено до 60. У детей до года нормальное содержание лимфоцитов колеблется между 40 и 42%. В возрасте до 6 лет процент элементов не должен превышать 65. После этого возраста уровень содержания вещества в крови постепенно снижается и к 20 годам должен достигнуть отметки 35-40%.
Если лимфоциты повышены, то это свидетельствует о развитии патологий или воспалительного процесса в организме. Чаще всего у взрослых людей спровоцировать такой процесс могут атипичные лимфоциты, вирусные заболевания, такие как ОРВИ, оспа, разновидности гепатита, корь. Повышенное содержание элементов в крови может говорить о развитии хронического или острого лимфолейкоза или туберкулеза. В редких случаях провоцировать рост количества лимфоцитов может гипертиреоз или лимфосаркома.
Когда лимфоциты понижены, это говорит о лимфоцитопении. Такое отклонение вызывает больше опасений, если оно обнаружено у взрослого человека. Если пониженное количество лимфоцитов наблюдается в крови у ребенка, то это может быть вызвано просто возрастными изменениями. Для подтверждения диагноза необходимо сделать еще несколько анализов.
Содержание базофилов
Общий анализ крови позволяет узнать точное содержание базофилов в плазме. Это элементы, которые принимают участие в реакции организма человека на аллергены. Расшифровка общего анализа дает возможность понять, какое количество клеток находится в плазме, и сделать вывод о работе целой системы организма. Базофилы выполняют свои основные задачи, попадая в ткани организма.
Базофилы защищают человеческий организм от влияния яда и токсических веществ. Если расшифровка показала, что в организме недостаточное количество элемента, то это свидетельствует о нарушении защитной системы организма. Атипичные базофилы не могут нормально выполнять свою функцию и защищать организм человека. Они являются одним из основных элементов, который стимулирует работу иммунной системы. Общий анализ крови должен показать процентное отношение базофилов к общему количеству лейкоцитов.
Стандартное количество таких клеток в плазме не должно превышать 2%. Если базофилы повышены, то это свидетельствует не только о нарушении работы иммунной системы, но и о развитии ряда заболеваний в организме пациента. Если общий анализ крови дал такой результат, то это значит, что у пациента может быть оспа, воспалительный процесс в желудочном тракте, тяжелые заболевания крови.
Но довольно часто у пациентов бывает просто аллергическая реакция, когда базофилы повышены. Понижение содержания элементов в крови у больных обычно сопровождается нарушением уровня гормонов, работы гипоталамуса или острыми инфекционными заболеваниями. Если при исследовании крови расшифровка показала пониженный уровень базофилов, то для женщин это может означать беременность.
Наличие эозинофилов
Содержаться такие компоненты должны только в пределах стандарта. Это значит, что их количество не должно быть более 5%. Такое обозначение результатов верно только для взрослого человека. У ребенка наличие эозинофилов в плазме может быть значительно выше. Бояться этого не стоит. Желательно просто провести более детальную диагностику, чтобы узнать, связано ли это с возрастными изменениями или нет.
Когда у больного эозинофилы повышены в анализе, то это — эозинофилия. Заболевание, которое спровоцировано повышенной активностью и аномальным количеством клеток. В 1 очередь такое поражение символизирует повреждение работы защитной иммунной системы организма. Провоцировать эозинофилию могут патологические заболевания крови, астма, лихорадка, отек легких, дерматит, лишай, демодекоз, артрит, волчанка, периартрит. Нередко провокатором заболевания становятся паразитические поражения организма. Если у человека подозрение на эозинофилию, то ему желательно сделать анализ на лямблии.
Если у пациента понижены в крови эозинофилы, то это говорит об эозинопинии. Это частичное или полное отсутствие данных клеток в плазме человека. Заболевание может развиваться как самостоятельно, так и в группе с другими болезнями крови. Нередко такое отклонение сопровождается лейкоцитозом. Это говорит о продолжительном и остром воспалении, которое происходит в организме больного.
Наличие лейкоцитов
Лейкоцитарная формула высчитывает количество элементов, которые содержатся в анализе относительно тех, что должны содержаться в плазме здорового человека. Определение содержания вещества не занимает много времени. В анализе должно быть лейкоцитов не более чем 9,0*109/л и не менее чем 4,0*109/л. Любое отклонение от этих значений объясняется наличием заболевания или аномалией. Такое значение актуально только для взрослых пациентов. Когда проводится детский анализ крови, расшифровка может быть несколько другой. Все зависит от того, сколько лет ребенку на момент исследования.
Атипичные лейкоциты провоцируют развитие болезней и воспалений в организме. Если их содержание очень большое, то это влияет на развитие лейкоцитоза. Есть несколько причин, которые способствуют прогрессированию заболевания. Если у пациента деформации стволовых клеток за счет опухоли, то это приводит к нарушению кровообмена и изменению уровня лейкоцитов. Влиять на рост количества клеток может повышенное содержание токсинов в организме или неправильная работа надпочечников.
Повреждение сосудов или их сильное расширение нередко провоцирует лейкоцитоз. Лейкоцитарная формула дает возможность понять, когда у больного пониженный уровень элемента в анализе. Такое отклонение часто встречается у людей которые болеют гепатитом, корью, ВИЧ. Заболевания брюшной полости нередко провоцируют подобную аномалию. Важно вовремя обнаружить болезнь и приступить к ее лечению.
Похожие записи:
Все права защищены. Использование любых материалов сайта допустимо только при соблюдении соглашения об использовании сайта и с письменного разрешения администрации.
Внимание! Все статьи, размещенные на сайте носят ознакомительный характер. Мы настоятельно рекомендуем Вам, по вопросам применения лекарственных препаратов и проведения медицинского обследования обращаться к врачу нужной квалификации! Не занимайтесь самолечением!
Источник: https://101analiz.ru/krov/razvernutyj/razvernutyj-analiz.html
Атипичные лимфоциты норма
Слово атипичные не дарит приятных ассоциаций, ведь атипичными называются измененные клетки организма, вызывающие появление рака. Тем не менее, если вам говорят, что у вас в крови повышены атипичные лимфоциты.
Оглавление:
не стоит бить тревогу и писать завещание. В этом случае атипичные значит необычные , то есть имеющие не свойственные лимфоцитам особенности. С онкологией они не имеют ничего общего и встречаются при совершенно других болезнях.
Что такое атипичные лимфоциты и как они выглядят:
Как известно, при раздражении антигенами, а также во время некоторых заболеваний (вирусные болезни, аллергии) показатели лимфоцитов повышаются. Наряду с этим некоторые из них меняют свои свойства и внешний вид.
Атипичные лимфоциты приобретают следующие особенности
Они становятся крупными. Обычно макрофаги – самые большие лейкоциты, а лимфоциты редко вырастают более чем до 12 мкм. Когда они становятся атипичными, их размер может составлять 30 мкм и более.
Нормальный лимфоцит имеет форму, близкую к округлой. Измененные же формы клеток приобретают неправильную, многоугольную форму, а их границы могут выглядеть рваными .
Ядро обычной клетки округлое или немного вытянутое. У атипичного лимфоцита оно может таким оставаться, однако зачастую бывает удлиненным, с изъеденными контурами, перетяжками или расщелинами. Бывает уменьшенным.
Если мазок крови, в котором изучают показатели лимфоцитов, окрасить стандартными красителями (для этого используют гематоксилин и эозин), то атипичные клеточки будут приобретать более яркую окраску, чем нормальные . Ядро их фиолетовое, а цитоплазма серая, темно-синяя либо голубая.
Если атипичные лимфоциты появились у пациента, зараженного цитомегаловирусом или вирусом Эпштейна-Барра, то их называют клетками Дауни. Дело в том, что в 1923 году американский врач-гематолог с такой фамилией одним из первых увидел их в микроскоп и описал их свойства.
Некоторые лимфоциты с атипичными свойствами также называют клетками Ридера, или амитотическими лимфоцитами. Их особенность состоит в том, что у них почкообразная форма и ядра с зазубренными контурами или перетяжкой посередине, разделяющей их на дольки.
Также среди атипичных лимфоцитов выделяют клетки Боткина-Клейна-Гумпрехта. Сразу три ученых описали специфические клетки, которые встречаются при лимфаденозах. Собственно, это не живые клетки, а их останки, которые какие-то время циркулируют в крови. За то, что их едва видно, эти лимфоциты еще называют клетками-тенями.
Где находятся атипичные лимфоциты:
Обнаруживают их главным образом в крови, так как именно кровь берут на анализ, чтобы изучить эритроциты, лейкоциты, лимфоциты и прочие важные показатели. Но в тканях их тоже немало.
В организме взрослого человека может быть 6% атипичных лимфоцитов, даже если этот человек полностью здоров. Когда же в связи с болезнью у пациента наблюдаются высокие лимфоциты в крови. то показатель атипичных может подниматься до 7-10% и выше.
Чем обусловлено появление атипичных лимфоцитов?
Когда человек болеет, и его организм нуждается в защите, иммунная система должна выработать достаточное количество лимфоцитов, чтобы они общими усилиями смогли справиться с агрессором. Увы, иногда ресурсов иммунитета на это не хватает. Клетки вырабатываются, однако не могут полноценно созреть и подготовиться к встрече с возбудителем или аллергеном. Так и получается, что в крови возрастает количество таких необычных лимфоцитов. Они выполняют нужные функции, но вот внешность у них не очень полноценна.
Стоит больному пойти на поправку, и картина крови тут же, всего за несколько дней, налаживается.
Иногда высокие лимфоциты в крови и появление атипичных форм наблюдаются не только при ОРВИ и аллергиях. но и в более серьезных ситуациях. К появлению их большого количества могут приводить коклюш, сифилис, туберкулез. лимфолейкоз, бруцеллез, токсоплазмоз, сывороточная болезнь.
Что делать, если в крови повышены атипичные лимфоциты?
Вариант только один: лечиться, принимая терапию, прописанную доктором. Это, в зависимости от природы заболевания, могут быть самые разные медикаменты и методики. Кроме того, по согласованию с лечащим врачом можно принимать препарат Трансфер Фактор .
Присутствие атипичных лимфоцитов указывает на то, что иммунная система человека работает в напряженном режиме. Это средство позволяет ей помочь. Оно создано на основе информационных молекул, извлеченных из коровьего молозива и яичных желтков. Молекулы обучают лимфоциты правильной работе, что ускоряет их образование, созревание и повышает работоспособность. Регулярный прием препарата помогает быстрее восстановить здоровье и вернуть нормальные показатели крови.
Атипичные лимфоциты
Атипичные или реактивные лимфоциты — это крупные лимфоциты, появляющиеся в результате антигенной стимуляции при инфекционных или аллергических заболеваниях. Атипичные лимфоциты в размере превышают 30 мкм, имеют неправильную форму.
Ядро атипичного лимфоцита может быть круглым, эллиптическим, с зазубренными контурами, расщелинами. Цитоплазмы больше чем в типичном лимфоците, выраженная базофилия (при окраске имеет насыщенно голубой цвет). Иногда присутствуют гранулы азурофильной зернистости, вакуоли. Чаще цитоплазма серого, голубого или темно-синего цвета.
Атипичные лимфоциты появляющиеся при цитомегаловирусной и эпштейн-барр вирусной инфекции называют клетками Дауни, по имени американского гематолога, описавшего их в 1923 году.
Реактивные лифоциты появляются в кровотоке в случае резкой необходимости в лимфоцитах. В таком случае лимфоциты просто не успевают «созреть» и приобрести полноценную морфологию. При стихании инфекционного процесс количество атипичных лимфоцитов резко снижается до нормы
Причины появления атипичных лимфоцитов в крови:
- Лимфолейкоз.
- Вирусная инфекция — инфекционный лимфоцитоз, инфекционный мононуклеоз, инфекционный гепатит, вирусная пневмония. экзантема в детском возрасте, паротит, ветрянка, цитомегаловирусная и эпштейн-барр вирусная инфекция.
- Коклюш .
- Бруцеллез.
- Сифилис (на некоторых стадиях).
- Токсоплазмоз.
- Реакции на лекарства и сывороточная болезнь.
У здоровых людей может быть до 6% атипичных лимфоцитов в анализе крови .
Папилломы — ПРИЗНАК наличия паразитов в теле! На ночь нужно пить кружку.
Наталья уже как щепка (-25 КГ за месяц)! Для этого она дважды в день.
Лимфоциты в крови: что значит превышение нормы у ребенка и взрослого
Лимфоциты в крови?
Получая на руки результаты сданных анализов крови или мочи, большинство обывателей с растерянностью читают непонятные обозначения, проценты и определение граничных показателей. А видя диковинные подписи, паникуют, считая, что им поставили неизлечимый диагноз. На самом деле, все не так печально: это специалисты лаборатории расшифровали лимфоциты в крови, указывая на возможные отклонения от нормы медицинскими терминами. Что означают эти показатели? Норма лимфоцитов в крови
Лимфоциты являются представителями белых кровяных телец, иначе – лейкоцитов (WBC). Это разношерстная группа клеток, разнообразных по строению, функциям: эозинофилы, базофилы, моноциты, нейтрофилы и лимфоциты. Последние называют важнейшими клетками иммунной системы. Они первыми определяют «чужака», распознают инородные антигены, вырабатывая механизм адекватного ответа на проникновение инфекций, вирусов.
Лимфоциты подразделяются на: В-клетки. Сталкиваясь с антигенами, В-лимфоциты производят антитела против конкретного вида проникших инородных структур. Периферическая кровь содержит от 8 до 20%. Т-клетки (цитотоксические лимфоциты) составляют до 70%. NK (Natural Killers) – клетки-убийцы чужеродных тел. Их число в крови невелико – от 5 до 10%. Атипичные лимфоциты, которые представлены: О-лимфоцитами (нулевыми клетками), не имеющими характерных для вышеуказанных клеток рецепторов. К-, Ь-, ЕК-лимфоцитами, которые действуют нестандартно: изменяют свойства, завися от антигена. Где образуются лимфоциты? За воспроизводство этих клеток отвечает красный костный мозг и его лимфатический отдел кроветворения. Распространенное мнение, что лимфоциты «блуждают» по крови, убивая известные только им вирусы – ошибочно. В периферической крови находится около 2% всего запаса лимфоцитов, остальные содержит лимфоидная ткань, лимфатические узлы.
Уровень лимфоцитов у взрослых в крови составляет от 25 до 40% общего количества белых кровяных телец – лейкоцитов. У женщин и мужчин этот показатель имеет незначительные отличия. Изменения гормонального фона, вызванные менструацией, при беременности, сказываются на качественных показателях клинического анализа крови: в этот период происходит увеличение удельного веса лимфоцитов до 50 – 55%. Если полученные результаты указывают на повышенное содержание в крови или их уровень значительно ниже нормы, могут быть назначены дополнительные исследования: Иммунофенотипирование лимфоцитов периферической крови. Этот метод генных исследований позволяет выявить точную структуру клеток, разграничивая причины отклонений от нормы на реактивные и опухолевые. Наличие в крови пролимфоцитов, лимфобластов свидетельствует о патологии в организме. Анализ на активированные лимфоциты. Рекомендуется врачом при затяжной болезни вирусного/инфекционного характера для определения течения заболевания, а также оценки эффективности назначенного лечения.
Детский организм до 13 – 15 лет имеет «собственное мнение» о количестве лимфоцитов в крови. Так, у грудничка первые 4 дня жизни превалируют в крови нейтрофилы, а с 5 нормальный уровень лимфоцитарных клеток увеличивается до 40-50%. С целью защиты от вирусных инфекций, природа сделала так, что у детей в возрасте одного года этот показатель составляет около 60%, постепенно снижаясь к 4 – 6 годам. В этом возрасте показатели нейтрофилов и лимфоцитов сравниваются, а по достижении 12-ти лет среди лейкоцитов вновь преобладают нейтрофилы.
Повышенное содержание лимфоцитарных клеток в крови называется лимфоцитозом. Важнейшим вопросом при этом является установление причины такой клинической картины. Превышение нормы может быть вызвано: Реактивным ответом на чужеродные тела. Снижение показателей до нормального состояния происходит в течение месяца-двух после выздоровления. Злокачественными образованиями. Чтобы исключить данный диагноз, проводятся дополнительные биохимические исследования, анализы.
Лимфоциты повышены у взрослого
Повышение лимфоцитарных клеток крови взрослого человека не сопровождается симптомами, а узнают о нем зачастую при лечении инфекционного заболевания. Проявляется как: Абсолютный лимфоцитоз – общее количество иммунных стражей организма резко возрастает как ответ на заболевание или патологию. Относительный лимфоцитоз – изменяется удельный вес лейкоцитов в структуре лейкоцитарной формулы: не меняя абсолютного значения в крови, они «вытесняют» другие клетки, например, нейтрофилы.
Причинами являются: Инфекционные заболевания вирусного типа. Хронические болезни. Аллергический ответ на некоторые виды медицинских препаратов. Перенесенные заболевания, которые требуют времени на восстановление защитных сил организма. Сдавая кровь на анализ в этот период, будьте готовы встретить «странные» расшифровки на карточках результатов: плазматизация цитоплазмы лимфоцитов – означает изменение структуры клетки, приближая ее по свойствам к моноцитам; лимфоцитоз гранулопения при беременности показывает наличие воспалительных инфекций у будущей мамочки. Эндокринные сбои организма. Лейкозы и лимфолейкозы.
Причины появления у детей
Высокие лимфоциты у деток в крови вызваны зачастую вирусными заболеваниями, которые помогают вырабатывать пожизненный иммунитет к кори, краснухе, паротиту, ветрянке и пр. Абсолютное повышение иммунных клеток порой сигнализирует о начинающемся ОРВИ или гриппе. Когда лимфоциты и моноциты повышены, особое внимание следует обратить на вероятность такого заболевания, как мононуклеоз. Если длительное время после выздоровления этих клеток все еще много в крови, необходимо обратиться к гематологу или онкологу.
Лимфоцитопения – состояние, характеризующееся пониженным содержанием лимфоцитов. Отличается снижением общего количества этих клеток относительно других лейкоцитов. Например, нейтрофилов при пневмониях, гнойных инфекциях становится больше, а лимфоциты падают. Абсолютная лимфопения характерна при заболеваниях, когда костный мозг не может продуцировать иммунные тела или производит незрелые клетки.
Низкие лимфоциты у взрослых.
Наличие лимфоцитов в крови ниже нормы не вызывает тревоги, если этот показатель связан с вирусной инфекцией (ОРВИ) в самом разгаре. Организм усиленно подавляет инородные тела за счет воздействия имеющихся иммунных клеток, а новые еще не сформированы. Аналогичный механизм наблюдается у лиц, страдающих ВИЧ-инфекцией, когда истощенный организм не успевает восполнять запасы лейкоцитов. При нарушениях деятельности органов, отвечающих за производство/созревание лимфоцитарных клеток, наблюдается стойкое, длительное снижение от нормы:
при беременности; анемии; при лечении кортикостероидами; болезни Иценко – Кушинга; при онкологии или после проведенной химиолучевой терапии.
Источник: https://orebenkah.ru/krov-u-detej/atipichnye-limfocity-v-krovi-u-rebenka.html
Атипичные лимфоциты в крови
Похожие и рекомендуемые вопросы
7 ответов
Судя по всему, это не гематология. Вы, видимо, переболели не ОРВИ, а инфекционным мононуклеозом, отсюда и такие клетки. У вас 3 выхода. Первый — на все наплевать. Второй- сдать кровь в лаборатории, где ее могут посмотреть специалисты (в лаборатории при гематологическом отделении). И третий, если не подходят первые два- пересдать анализ крови через месяц, но не на гематологическом анализаторе, а с ручным подсчетом формулы крови, что могут сделать в любой поликлинической лаборатории. Но не на анализаторе, которые и там стоят. Нужно чтобы посчитал врач-лаборант.
Атипичные лимфоциты: что это такое, и почему появляются?
Содержание
Особенности атипичных лимфоцитов
- реактивный. Он развивается, если защитные силы организма ослабевают. Тогда появляется большое количество атипичных клеток, которые обладают неполноценными свойствами;
- постинфекционный. Он возникает, когда человек вылечился от вирусной или инфекционной болезни;
- злокачественный. Это состояние возникает у людей, которые страдают онкологическими заболеваниями. При этом также вырабатывается большое количество атипичных белых кровяных телец.
- Меняется их размер. В обычном состоянии самые большие лейкоциты — макрофаги достигают в размере не более двенадцати микрометров. Лимфоциты очень редко имеют большие размеры, но под воздействием вирусов они могут вырастать до тридцати микрометров. Именно такими являются атипичные лейкоциты.
- В нормальном состоянии лимфоцит круглой формы. Когда структура клеток меняется, они могут становиться многоугольными с рваными гранями.
- Подвергаются изменениям и ядра лимфоцитов. В анализе крови можно обнаружить, что у атипичного лейкоцита ядро удлиняется и покрывается расщелинами, тогда как в обычном состоянии имеет круглую форму, удлиненную совсем незначительно.
- Меняется и цвет лейкоцитов. Так, процедура анализа крови включает определение окраса клеток крови. Для этого во взятый у пациента биоматериал добавляют гематоксилин и эозин. Это стандартные красители. Во время этой процедуры можно увидеть, что реактивные или атипичные лейкоциты имеют более яркий окрас, чем обычные. Они обретают темно-серый или синий цвет с фиолетовым ядром.
- клетки Дауни. Их открыли в 1923 году. Ученый обнаружил эти клетки у больных, зараженных цитомегаловирусом или вирусом Эпштейна-Барра;
- клетки Ридера или амитотические лимфоциты. Они отличаются от других тем, что их ядро разделено пополам и имеет зазубренные контуры, а сама клетка почкообразной формы;
- клетка Боткина-Клейна-Гумпрехта. Над их описанием работали сразу трое ученых. Подобные лейкоциты обнаруживаются при лимфаденозе. Это мертвые клетки, которые некоторое время находятся в крови. Обнаружить их очень трудно, поэтому их еще называют тенями.
Почему они появляются
- Лимфолейкоза — это онкологическое заболевание, которое заключается в поражении злокачественными клетками лимфатической ткани.
- Бруцеллеза — это инфекция, которой страдают домашние животные. К человеку она попадает через продукты животного происхождения и поражает нервную и сердечно-сосудистую системы, а также кости и суставы.
- Некоторых стадий сифилиса — венерической инфекции, которая характеризуется поражением кожи, слизистых оболочек, внутренних органов, костей и нервной системы.
- Токсоплазмоза — инфекции, которая обычно протекает бессимптомно и вызывается токсоплазмами. Переносят инфекцию обычно кошки.
- Вирусных инфекций, например, пневмонии, ветрянки, которой чаще всего болеют дети, гепатита и других.
- Некоторых лекарственных препаратов, а также во время лечения иммунными сыворотками животного происхождения.
Что делать, если обнаружили лимфоциты реактивные
- если появились отеки, назначают противоаллергические препараты;
- при бактериальных инфекциях не обойтись без антибиотиков;
- желательно укреплять иммунитет. Для этого врач может назначить витаминно-минеральные комплексы, также необходимо вести здоровый образ жизни, правильно питаться, заниматься спортом.
Атипичные лимфоциты
Атипичные лимфоциты в анализе крови: стоит ли паниковать?
В чём проявляется атипичность лимфоцитов?
Причины появления атипичных лимфоцитов
- Приём определённого круга лекарственных препаратов (к примеру, иммунных сывороток органического происхождения);
- Инфекционные заболевания: пневмония, ветрянка, гепатит и т.д.
- Бруцеллёз — заболевание, поражающее домашних животных. Попадая в организм человека через продукты питания, может вызывать нарушение в работе различных систем, в том числе и иммунной;
- Токсоплазмоз — заболевание без явной клинической картины, поражающее, однако, иммунные клетки организма и приводящее к возникновению реактивных лимфоцитов;
- Лимфолейкоз — злокачественное поражение лимфатических узлов, характеризующееся накоплением в них раковых клеток;
- Коклюш — заболевание дыхательных путей, сопровождаемое судорожным кашлем. Чаще всего встречается у детей;
- Сывороточная болезнь — аллергия на препараты животного происхождения;
- Сифилис на некоторых стадиях.
Норма атипичных лимфоцитов и лечение
- Витаминно-минеральную терапию, укрепляющую иммунитет.
- Если заболевание имеет вирусную природу, соответственно назначаются антибиотики и противовирусные препараты.
- Антигистаминные и противоаллергические лекарства, если образование атипичных лимфоцитов спровоцировано аллергией.
О чем говорит наличие атипичных лимфоцитов в крови, и стоит ли волноваться?
Внешние отличия атипичных лейкоцитарных клеток
- Нестандартная форма. Нормальные лимфоциты округлые. Атипичность клетки проявляется в рваном контуре или многогранной форме.
- Увеличенный или уменьшенный размер. Обычный размер лимфоцита – около 12 мкм. Атипичные формы могут достигать размеров моноцитов (до 30 мкм).
- Видоизменённое ядро. При оценке морфологии клетки смотрят на соотношение размеров ядра с объемом цитоплазмы. Незрелые нейтрофилы не имеют сегментированного ядра, а ядро атипичного лимфоцита, наоборот, может состоять из нескольких сегментов. Атипичные лимфоциты имеют увеличенную плазму, их называют плазматизированными. Базофильность плазмы говорит о молодости этих клеток.
- Нетипичное окрашивание клетки красителями, зернистость цитоплазмы. При обработке атипичных лимфоцитов эозиновым красителем они окрашиваются в синий цвет. Ядра становятся фиолетовыми. Нормальные лимфоциты после подкрашивания становятся жемчужными, сероватыми или желтоватыми.
Причины появления атипичных клеточных форм
- Вирусные и бактериальные инфекции;
- Интоксикация организма;
- Ионизирующее излучение;
- Рак и генетические патологии.
Виды атипичных лейкоцитарных клеток и причины появления
Дегенеративные изменения
Атипичные мононуклеары
Называются клетками Дауни или лимфомоноцитами из-за морфологического сходства атипичных лимфоцитов этого типа с моноцитами. По размерам они крупнее обычных лимфоцитов, имеют моноцитарное ядро. Эти клетки чаще всего обнаруживают в крови.
Важно! Лечение препаратами сыворотки крови тоже может стать причиной усиления лейкопоэза.
Клетки-тени Боткина-Гумпрехта
Клетки Ридера
Норма атипичных лимфоцитов, меры по нормализации
Главное о лимфоцитах: атипичность и норма
- Кровяные тельца WBC со сложным ядром и наличием в цитоплазме гранул (называются гранулоцитами – базофилы, эозинофилы, нейтрофилы);
- Кровяные тельца WBC с простым ядром и цитоплазмой без зернистости (называются агранулоцитами – лимфоцитами и моноцитами).
В этот раз остановимся подробнее на лимфоцитах.
Виды и функции
Т-клетки
В-клетки
NK-клетки
Образование клеток-лимфоцитов
Норма
Атипичные кровяные тельца
- Клетки имеют общий увеличенный размер. Некоторые из них достигают 30 мкм и даже больше (в среднем – не более 12 мкм);
- Изменённые кровяные тельца имеют неправильную, угловатую, многоугольную форму. Нередко границы атипичных клеток выглядят «покусанными» или рваными (очертания нормальной клетки близки к окружности);
- Ядро может оставаться нормальным (практически круглым или слегка вытянутым) или иметь внешние дефекты: изъеденные края, расщелины и перетяжки, вытянутый или уменьшенный вид;
- Нетипичные тельца крови окрашиваются интенсивнее, имеют синий или серый цвет различной интенсивности и ярко-фиолетовое ядро.
Причины появления нестандартных лимфоцитов
- Коклюш;
- Туберкулёз;
- Сифилис;
- Лимфолейкоз;
- Токсоплазмоз;
- Бруцеллёз;
- Сывороточная болезнь;
- Вирусное инфицирование.
Атипичные лимфоциты
Слово «атипичные» не дарит приятных ассоциаций, ведь атипичными называются измененные клетки организма, вызывающие появление рака. Тем не менее, если вам говорят, что у вас в крови повышены атипичные лимфоциты, не стоит бить тревогу и писать завещание. В этом случае «атипичные» значит «необычные», то есть имеющие не свойственные лимфоцитам особенности. С онкологией они не имеют ничего общего и встречаются при совершенно других болезнях.
Что такое атипичные лимфоциты и как они выглядят:
Они становятся крупными. Обычно макрофаги – самые большие лейкоциты, а лимфоциты редко «вырастают» более чем до 12 мкм. Когда они становятся атипичными, их размер может составлять 30 мкм и более.
Где находятся атипичные лимфоциты:
Чем обусловлено появление атипичных лимфоцитов?
Когда человек болеет, и его организм нуждается в защите, иммунная система должна выработать достаточное количество лимфоцитов, чтобы они общими усилиями смогли справиться с агрессором. Увы, иногда ресурсов иммунитета на это не хватает. Клетки вырабатываются, однако не могут полноценно созреть и подготовиться к встрече с возбудителем или аллергеном. Так и получается, что в крови возрастает количество таких необычных лимфоцитов. Они выполняют нужные функции, но вот «внешность» у них не очень полноценна.
Что делать, если в крови повышены атипичные лимфоциты?
Вариант только один: лечиться, принимая терапию, прописанную доктором. Это, в зависимости от природы заболевания, могут быть самые разные медикаменты и методики. Кроме того, по согласованию с лечащим врачом можно принимать препарат Трансфер Фактор.
г. Москва ул. Верхняя Радищевская д.7 стр.1 оф. 205
Источник: https://www.transferfaktory.ru/atipichnyie-limfotsityi
Появление атипичных лимфоцитов в анализе крови
Что делать, когда в анализе крови обнаруживаются атипичные лимфоциты? Данный вопрос беспокоит многих людей, получивших результаты исследования биологического материала, сданного на анализ.
Если и вы хотите получить ответ на вопрос и узнать про причины появления атипичных лимфоцитов, то читайте статью.
Общая информация
Лимфоцитами называют разновидности клеток крови, отвечающих за защитные процессы организма при его поражении различными заболеваниями.
Атипичные лимфоциты являются модификацией «стандартных» белых кровяных телец, отличающихся размерами и «рабочими» свойствами.
В идеале у здорового взрослого человека или ребенка количество лимфоцитов в крови должно попадать в границы пределов референтной нормы.
Количество телец значительно возрастает тогда, когда организм пациента приступает к борьбе с какой-либо проблемой, поражающей ткани, органы или иммунную систему.
Состояние, при котором лимфоциты повышены, называют лимфоцитозом. Иногда патология может наблюдаться и у внешне здоровых людей, не имеющих жалоб на какие-либо проблемы с самочувствием.
В таком случае при выявленном и подтвержденном повторными анализами лимфоцитозе пациентам следует посетить профильного врача – гематолога, занимающегося исследованием патологий крови.
Атипичные лимфоциты бывают различных видов. Данные виды названы в честь врачей, исследовавших болезни крови и впервые обнаруживших тот или иной вид атипичных клеток.
Первая группа атипичных телец называется клетками Дауни. Впервые они были выявлены в первой трети двадцатого века у пациентов, страдающих от патологий, спровоцированных наличием цитомегаловируса или вируса Эпштейна-Барра.
Вторая группа атипичных лимфоцитов названа в честь известного гематолога Ридера, исследовавшего различные патологии крови своих пациентов.
Ридер выявил, что у многих из тех, кто страдали от острой лейкемии, лимфоциты приобретают иное строение.
В частности, ядра таких лимфоцитов словно разделены пополам и обладают неравным контуром. Иногда тельца данной группы называют амитотическими.
Третья группа атипичных лимфоцитов называется клетками Боткина-Клейна-Гумпрехта. Основное заболевание, провоцирующее появление данных атипичных телец, – лимфаденоз.
Клетки данного вида не обладают какими-либо полезными функциями, но при этом постоянно находятся в крови пациентов, страдающих от патологий. В некоторых медицинских источниках можно встретить альтернативное название данных атипичных лимфоцитов, звучащее как «тени Боткина-Клейна-Гумпрехта».
Разновидности атипичных лимфоцитов
Атипичные лимфоциты появляются в организме под воздействием различных антигенов. Главной отличительной чертой является увеличенный размер клеток.
Для сравнения, размер «стандартных» телец колеблется в районе десяти – двенадцати микрометров, размер атипичных лимфоцитов составляет около тридцати микрометров.
Стандартные лимфоциты имеют характерную круглую форму, а лимфоциты, обладающие атипичным происхождением, могут видоизменяться, превращаясь в многоугольные клетки, обладающие неравномерными по длине рваными гранями.
Главные изменения, специфические для атипичных лимфоцитов, происходят внутри их ядер.
В ходе лабораторного исследования данных клеток можно обнаружить, что внутри них располагаются не обычные, гладкие и слегка удлиненные ядра, а ядра вытянутой формы, покрытые микротрещинами и небольшими вмятинами.
Анализ крови, направленный на выявление атипичных телец, предполагает использование специализированных реактивов, позволяющих правильно оценить окрас клеток.
В качестве дополнительных реактивов традиционно используются вещества, называемые «гематоксилином» и «эозином».
После взаимодействия с данными веществами лимфоциты атипичного вида, находящиеся в составе биологического материала пациента, взятого на анализ, приобретают темно-серый или синеватый цвет, причем их ядра окрашиваются в оттенки фиолетового цвета. Классические лимфоциты имеют жемчужный, слегка сероватый или желтоватый оттенок.
Повышенное количество лимфоцитов в крови пациента может быть спровоцировано различными факторами. Выделяют реактивный, постинфекционный и злокачественный лимфоцитоз.
Реактивный лимфоцитоз появляется вследствие значительно ослабленного иммунитета.
Организм, незащищенный даже от не самых значительных патологических ситуаций, порождает большое количество как обычных, так и атипичных телец, обладающих большими размерами и неспособных эффективно бороться с заявленными проблемами.
Постинфекционный лимфоцитоз является наиболее безопасным для человека, так как носит временный характер.
Основной причиной его появления называют вирусные или инфекционные заболевания, перенесенные в недавнем прошлом.
Злокачественный лимфоцитоз – патологический симптом, характерный для людей, страдающих от каких-либо онкологических заболеваний.
Онкология стимулирует организм человека вырабатывать огромное количество лимфоцитов, часть из которых перерождается в атипичные клетки.
Причины появления
Если анализ крови покажет присутствие в биологическом материале атипичных лимфоцитов, то не стоит паниковать и думать о плохом.
В подавляющем большинстве случаев их нахождение будет оправдано недавно перенесенными вирусными заболеваниями или различными аллергическими процессами, протекающими в тканях организма.
Чтобы нивелировать проблему и не спровоцировать развитие более серьезных патологических ситуаций, следует заняться восстановлением иммунной системы.
После ее восстановления иммунитет перестанет производить на свет неполноценные, атипичные кровяные тельца и вновь будет готов к борьбе с возможными заболеваниями.
Однако в некоторых случаях наличие атипичных телец в крови у ребенка или взрослого может указывать на ряд достаточно серьезных патологий, которые требуют либо незамедлительного (и зачастую радикального) лечения либо тщательного контроля врача над их течением.
Речь идет о таких патологиях, как:
- лимфолейкоз (поражение лимфатической системы раковыми клетками);
- бруцеллез (заболевание инфекционного спектра, передающееся людям от контакта с животными и негативным образом сказывающееся на правильной работе нервной и сердечно-сосудистой систем);
- сифилис (инфекция, поражающая слизистые ткани, костную и нервную систему);
- токсоплазмоз (заболевание, не имеющее ярко выраженных симптомов, но при этом в острой форме разрушающее все системы организма);
- пневмония, ветрянка, гепатит и проч.
Кроме того, появление атипичных лимфоцитов в организме человека может быть вызвано длительным лечением каких-либо патологий, в ходе которого использовались специализированные сыворотки животного происхождения, предназначенные для повышения радикально ослабленного иммунитета.
Данные сыворотки могут восприниматься телом пациента, получающего лечение, в качестве инородных реагентов, поэтому его организм может начать бороться с компонентами, входящими в их состав, используя остатки собственной, но изрядно истощенной иммунной системы.
Лабораторные анализы и лечение проблемы
Чтобы выявить наличие или отсутствие атипичных лимфоцитов в биологическом материале пациента, врачи направляют человека на сдачу общего анализа крови, подразумевающего детальное исследование уровня и разновидностей лейкоцитов, эритроцитов, лимфоцитов и тромбоцитов.
Чтобы получить направление на анализ, следует посетить терапевта – врача общей практики, или гематолога – доктора, специализирующегося на лечении заболеваний крови.
Впрочем, дать направление на данный анализ могут и другие профильные врачи в том случае, когда заподозрят у пациента, жалующегося на определенные симптомы, какие-либо проблемы со здоровьем, предполагающие наличие атипичных телец.
Состояниям, для которых характерно появление атипичных лимфоцитов в крови, в одинаковой степени подвержены как взрослые люди, так и маленькие дети, обладающие сниженным иммунитетом, не способным самостоятельно, без помощи лекарственных средств, бороться с возникающими заболеваниями.
Лечение проблемы, для которой характерно повышение данного показателя, симптоматическое и зависит от вида патологии-катализатора процесса выработки атипичных лимфоцитов.
Если причиной всему – аллергия, то больным назначают прием антигистаминных препаратов.
Тогда, когда появление атипичных телец вызывается различными бактериальными инфекциями, используют антибиотики узкого или широкого спектра действия.
При наличии более серьезных патологий у пациентов им назначают комплексное лечение, состоящее из нескольких фаз.
Лимфоциты атипичного вида, обнаруженные в общем анализе крови – повод для проведения дополнительных уточняющих исследований биологического материала.
В норме они должны отсутствовать в человеческом организме. Чтобы исключить риск появления или прогрессирования каких-либо патологических ситуаций, для которых характерно появление данного показателя, следует внимательно прислушиваться к рекомендациям лечащего врача.
Источник: https://moydiagnos.ru/analizi/krovi/atipichnye-limfotsity.html












Комментарии 0